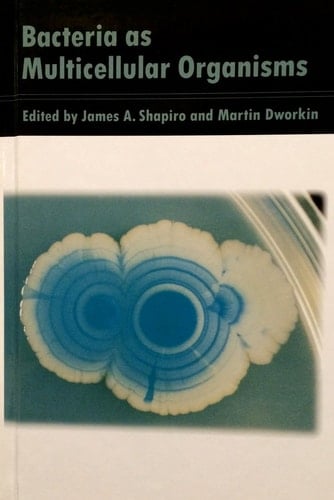
Bacteria as Multicellular Organisms

Bacteria as Multicellular Organisms is the first book devoted specifically to multicellular aspects of bacterial life. Contrary to conventional wisdom, which treats bacteria as autonomous single cells, this book shows how bacteria are sentient, interactive organisms with an unexpectedly broad repertoire of chemical and physical mechanisms for signaling each other and organizing themselves into multicellular aggregates with novel properties. The book has been compiled from reports by specialists in a variety of disciplines from genetics and microbiology to environmental engineering and biotechnology. This interdisciplinary approach reflects the growing importance of bacteria as key experimental material for investigating phenomena common to many fields in contemporary science: communication, complexity, self-organization, and pattern formation. The impact of bacterial multicellularity will affect such diverse areas as evolutionary population biology, non-linear dynamics, and information science.
Page Count:
480
Publication Date:
1997-02-06
ISBN-10:
0195091590
ISBN-13:
9780195091595
No comments yet. Be the first to share your thoughts!